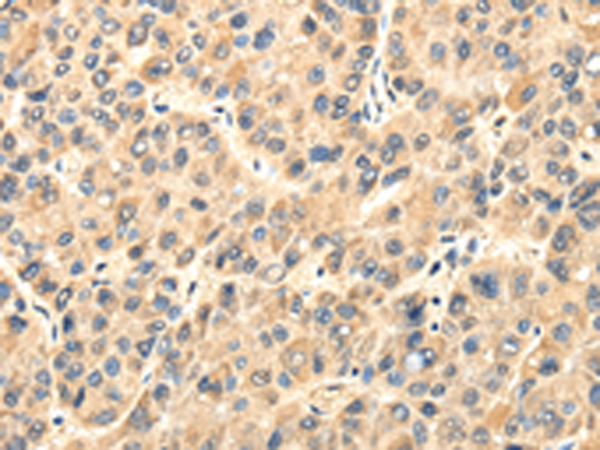

中文名稱: 兔抗TWIST2多克隆抗體
|
Background: |
The protein encoded by this gene is a basic helix-loop-helix type transcription factor and shares similarity with Twist. This protein may inhibit osteoblast maturation and maintain cells in a preosteoblast phenotype during osteoblast development. This gene may be upregulated in certain cancers. Mutations in this gene cause focal facial dermal dysplasia 3, Setleis type. Two transcript variants encoding the same protein have been found. |
|
Applications: |
ELISA, IHC |
|
Name of antibody: |
TWIST2 |
|
Immunogen: |
Full length of human TWIST2 |
|
Full name: |
twist family bHLH transcription factor 2 |
|
Synonyms: |
FFDD3; DERMO1; SETLSS; bHLHa39 |
|
SwissProt: |
Q8WVJ9 |
|
ELISA Recommended dilution: |
2000-5000 |
|
IHC positive control: |
Human liver cancer |
|
IHC Recommend dilution: |
25-100 |
購物車
購物車 幫助
幫助
 021-54845833/15800441009
021-54845833/15800441009
